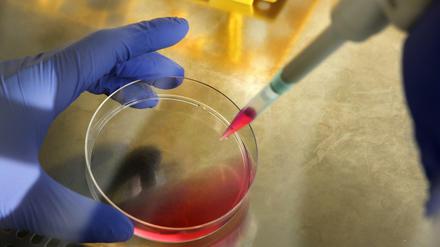

Fachleute warnen vor einem katastrophalen Kollaps der Ökosysteme, Bürger wollen Insekten besser geschützt sehen. Ein Überblick über Problem und Lösungsansätze.

Fachleute warnen vor einem katastrophalen Kollaps der Ökosysteme, Bürger wollen Insekten besser geschützt sehen. Ein Überblick über Problem und Lösungsansätze.

Nach 15 Jahren ist die Mission des Marsrovers „Opportunity“ zuende. Ein Nachruf – und ein Ausblick auf Möglichkeiten in der Zukunft auf dem Nachbarplanten.
Die europäische Forschungsinitiative "Restore" unter Leitung des Berlin Institute of Health bekommt eine Million Euro, um neuartige Therapien voranzubringen.

Finanzschwache Studierende brauchen Hilfe, meint der Verein Arbeiterkind.de. Doch weitere Spendenkampagnen soll es nicht geben.

Er heißt, oder hieß, Opportunity. Das bedeutet "Möglichkeit". Drei Monate sollte der Marsrover arbeiten. Es wurden 15 Jahre. Nun herrscht endgültig Funkstille.
öffnet in neuem Tab oder Fenster